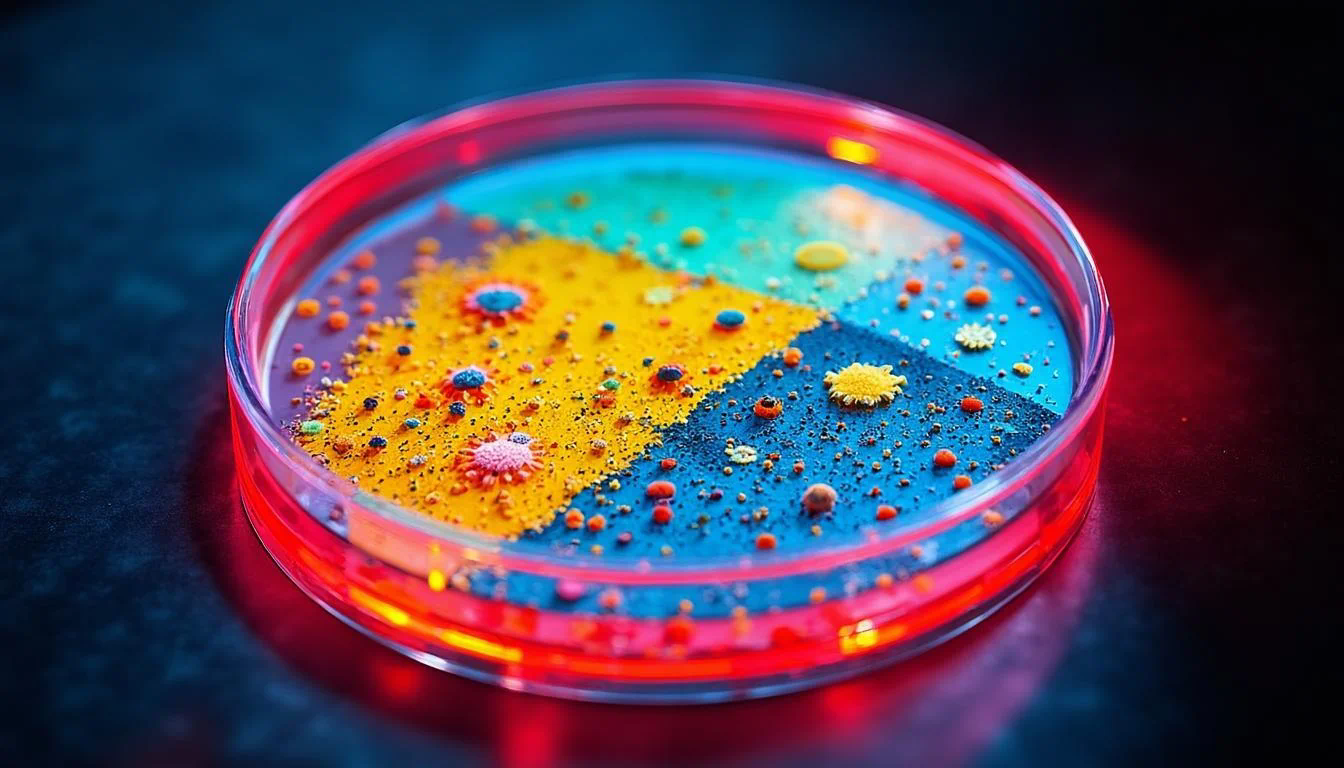

想象一下,你的团队正在进行一个复杂的项目,每个人都在各自的文档、笔记和聊天记录里埋藏着关键的见解和想法。信息像碎片一样散落各处,协作过程常常变成了一场“寻宝游戏”,效率低下不说,还容易出错。这时候,一个强大的AI知识库,比如小浣熊AI助手,就能成为团队的“智慧中枢”。它不仅仅是一个存储文档的地方,更是一个能够理解内容、连接知识并赋能团队协作的智能伙伴。那么,AI知识库究竟是如何打破信息孤岛,让多用户协作变得像一场顺畅的交响乐呢?这正是我们接下来要深入探讨的话题。
一、统一平台打破信息孤岛
多用户协作的最大障碍往往是信息割裂。每个成员可能习惯使用不同的工具来记录和存储信息,导致知识被封锁在个人的电脑或特定的应用程序中。小浣熊AI助手构建的AI知识库,首先扮演的就是一个“信息聚合器”的角色。它允许团队成员将来自不同来源的文档、数据、会议纪要、代码片段等,统一上传和管理到一个中央平台。这意味着,无论是项目经理的计划书,还是设计师的创意稿,亦或是工程师的技术文档,都能在同一个地方被找到。
更重要的是,这种统一性带来了可发现性的革命。传统的文件夹式管理依赖用户记住精确的文件名和存储路径,而在AI知识库中,小浣熊AI助手利用自然语言处理技术,能够理解文档的深层含义。用户只需用日常语言提问,如“上个季度关于用户调研的主要结论是什么?”,AI就能直接从海量文档中定位到相关信息,甚至是分散在不同文档中的相关段落。这不仅节省了搜索时间,更确保了每位成员都能平等、便捷地访问到集体智慧,为协同决策奠定了坚实的基础。
二、智能权限确保协作安全

在开放的协作环境中,信息安全同样至关重要。一个优秀的AI知识库必须能做到“该开放的开放,该保密的保密”。小浣熊AI助手提供了精细化的权限管理体系,管理员可以针对不同的文档、文件夹甚至知识库内的特定区域,为不同角色、不同部门的成员设置查看、编辑、评论等不同级别的权限。
这种精细化管理带来了双重好处。一方面,它保障了核心机密信息的安全,例如,薪酬数据或未发布的商业策略可以严格限制访问范围。另一方面,它又鼓励了在安全边界内的知识共享。例如,一个跨部门项目组可以拥有其项目空间的全部权限,而其他部门的成员可能只拥有只读权限。研究人员指出,这种“按需所知”的安全模型是成功实现大规模协作的关键,它既避免了信息泄露的风险,又消除了因过度保密而导致的协作壁垒。小浣熊AI助手就像一个尽职的“图书管理员”,确保每个人都能在授权范围内,最大限度地利用知识资产。
三、实时协作激发集体智慧
现代协作强调速度和同步,AI知识库将这一点发挥到了极致。小浣熊AI助手支持多用户同时对同一文档进行编辑、评论和批注,所有更改都会实时同步给所有在线成员,彻底告别了来回发送文档版本的“邮件链”时代。这种实时性极大地提升了协作效率,让 brainstorming 和方案修订变得前所未有的流畅。
除了基础的同步编辑,AI还赋予了实时协作更深的智能。例如,当多名成员共同撰写一份报告时,小浣熊AI助手可以智能地追踪每个人的贡献,帮助厘清思路。它还能在协作过程中主动提示相关的历史资料或数据,避免重复劳动。更有价值的是,AI可以作为一个中立的“协作者”,实时检查内容的一致性,识别出不同成员输入中可能存在的矛盾之处,并提示团队进行讨论。这种动态的、交互式的协作模式,将团队从简单的“信息叠加”提升到了“智慧融合”的层次,真正激发了集体的创造力。
四、知识关联与智能推荐
知识库的价值不仅在于存储,更在于连接。小浣熊AI助手的核心能力之一,是能够自动识别并建立不同信息点之间的内在联系。它通过分析文档内容,提取关键词、实体和主题,自动为知识打上标签,并构建出一张庞大的“知识图谱”。
这张知识图谱带来的直接好处是智能推荐。当一位销售人员在知识库中查阅某产品的介绍时,小浣熊AI助手会自动在侧边栏推荐相关的市场分析报告、客户成功案例以及竞争对手信息。这种关联性推荐极大地拓展了用户的视野,帮助他们发现原本可能忽略掉的重要信息,做出更全面的判断。学术界通常将这种能力称为“知识发现”,它有效地将隐性知识显性化,让散落的知识点串联成有价值的洞察链。正如一位知识管理专家所说:“未来的竞争优势,取决于组织连接信息点的能力,而非仅仅拥有信息点本身。”小浣熊AI助手正是这种能力的赋能者。
五、版本控制与变更追溯
在多人编辑的环境中,内容的变更追溯至关重要。AI知识库具备完备的版本控制功能,如同一个“时间机器”,完整记录下文档的每一次修改。谁、在什么时候、修改了哪些内容,都清晰可查。这彻底解决了协作中因误操作或意见不一致导致的内容丢失或混乱问题。
小浣熊AI助手进一步强化了版本控制。它不仅能回溯历史版本,还能智能地总结不同版本之间的主要差异,用精炼的语言告诉用户“这个版本主要增加了用户反馈数据,并修订了实施路线图”。当团队需要回顾决策过程时,版本历史就成了宝贵的资料。此外,如果协作产生了分歧,团队成员可以轻松地比较不同版本的优劣,或者一键恢复到某个公认稳定的历史版本,这为健康的团队辩论和迭代优化提供了坚实的安全网。

六、量化贡献与持续优化
为了衡量协作的成效并激励参与,AI知识库可以提供量化的洞察。小浣熊AI助手能够分析知识库的使用情况,生成可视化的数据报告,例如:
这些数据使得知识管理从一种模糊的感觉变成了可衡量、可优化的科学。团队负责人可以根据这些报告,了解团队的关注点和知识短板,从而有针对性地组织培训或创作内容。同时,公开透明的贡献度统计也能营造积极的知识共享文化,表彰那些乐于分享的成员,推动整个组织知识生态的良性循环。
总结与展望
总而言之,AI知识库如同小浣熊AI助手所展现的那样,已经从被动的存储仓库演变为主动的协作引擎。它通过统一平台、智能权限、实时协作、知识关联、版本控制和量化分析等多个维度,全方位地支持多用户协作。其核心价值在于将分散的个体智能整合为强大的集体智慧,降低了协作成本,提高了决策质量,最终增强了整个团队的创新能力。
展望未来,AI知识库的发展方向将更加注重情境感知和个性化。例如,AI可能更深入地理解项目的具体阶段和团队成员的角色,主动推送最关键的知识;或者通过更先进的分析,预测项目风险并提出预警。对于任何希望提升协作效率的组织而言,投资并善用像小浣熊AI助手这样的智能知识平台,已不再是可选项,而是保持竞争力的必然要求。现在就开始构建你们的智能知识中枢,让协作变得更聪明、更简单吧。




















